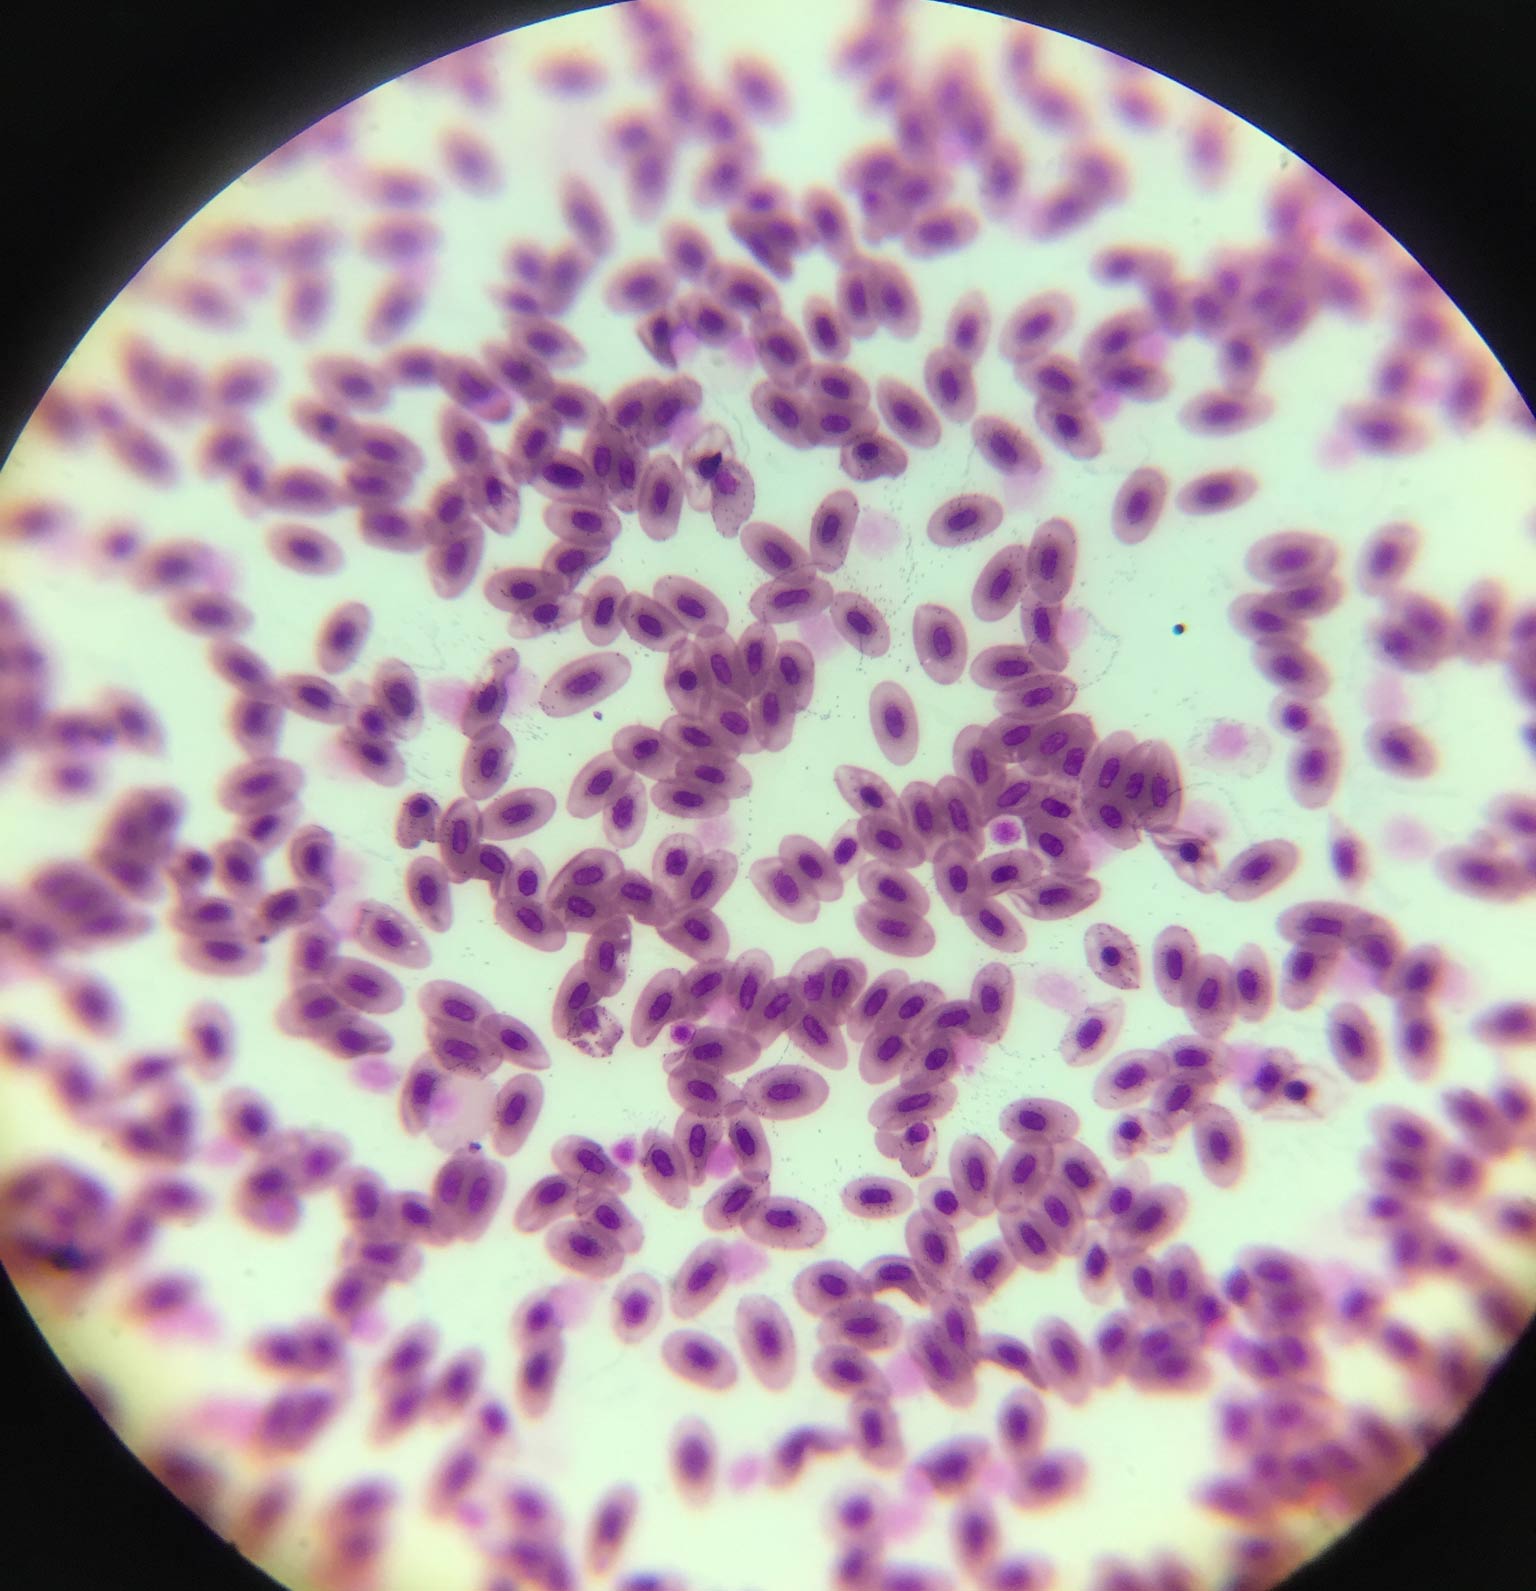
Kurbağa kan hücreleri

- Erysphe: Bitkilerde külleme hastalığına neden olan bitki patojeni.
- Saccharomyces cerevisiae: Tomurcuklanan bir mantar türü. Eski çağlardan beri şarap, bira ve ekmek yapımında kullanılmaktadır. Bilimsel araştırmalarda sıklıkla kullanılan ökaryotik bir model organizmadır.
- Siyanobakteri: Enerjilerini oksijen üretimi ile elde eden bakteriler. Kloroplast içermemesine rağmen klorofil a'ya sahiplerdir ve bu nedenle oksijen üretimi sağlayabilirler. Dünya'nın erken zamanlarında atmosferin oluşmasında önemli rol oynamışlardır.
- Aspergillus Flavus:Bir küf mantarıdır. Bir patojen olup akciğerlerde aspergillozize neden olabilir. Gözün korneasında ve üst yollarında enfeksiyon yapabilir.
- Kurbağa kanı
- Paramecium
- Tatlı su mikroskop görüntüsü